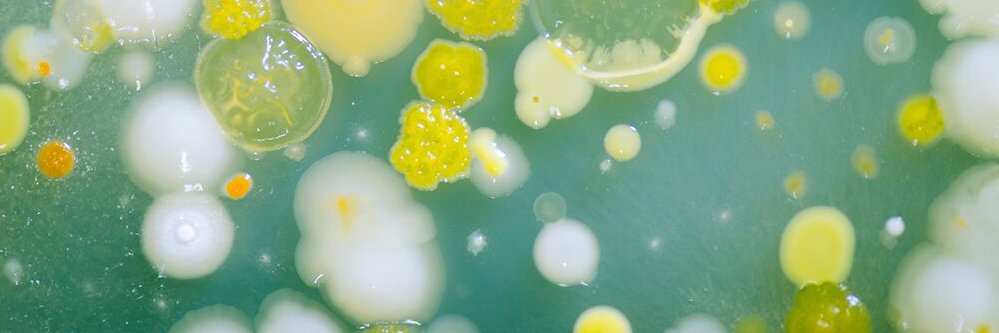
BES MicrobialEcology banner

BES MicrobialEcology
867 posts

BES MicrobialEcology
@BES_Microbial
The Microbial Ecology Group of the British Ecological Society


🚨JOB ALERT🚨 @NatureMetrics are looking for a Bioinformatics Research Scientist and a Junior Bioinformatician. Must have experience analysing metabarcoding and/or metagenomics data. Remote working will be considered. Please RT! naturemetrics.co.uk/careers/curren…


We are excited to announce the workshops running at a Festival of Ecology. Workshops are interactive sessions encouraging networking, skills development, and creative thinking. All session will be run live. #BES2020 ow.ly/zLrG50BPYRV

Our preprint is out: we found that fish gut microbiomes are vulnerable to coral reef habitat degradation @JSourisse & I w/@rfpreziosi @phylogenomics Catalina Guerra Jarrod Scott @M_helvetiae Andrew Altieri Owen McMillan @Matt_Leray disq.us/t/3rszdvm @stri_panama @EcolGenLab




I am very excited to announce that 2 PhD positions are available in my group to work on the ecology and evolution of metabolic cross-feeding interactions in soil-living bacterial communities. Please RT DM me in case of questions. More information here: shorturl.at/uN245

Just under 2 hours til the #ESA2020 live discussion on committing to diversity. @MethodsEcolEvol has an open call for Associate Editors & is committed to inclusion. More info: britishecologicalsociety.org/faqs-from-the-…






